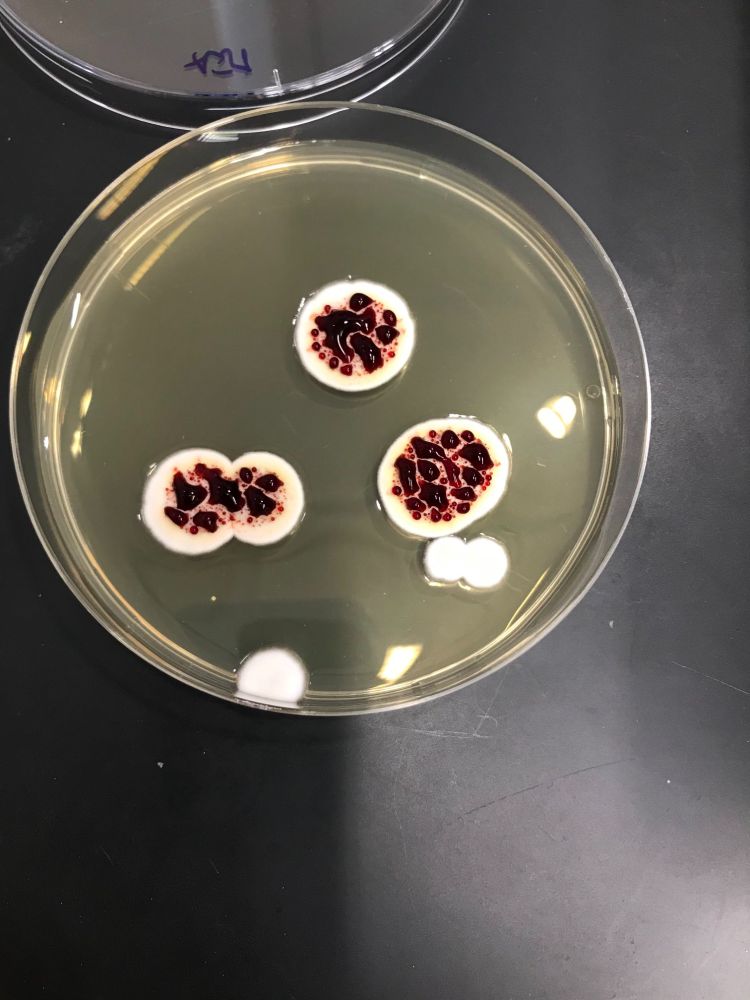

Member: IUCN SSC Aquatic Fungi Specialist Group
www.sciencedirect.com/science/arti...

www.sciencedirect.com/science/arti...
Picture of Penicillium krskae by Roman Labuda.
Picture of Penicillium krskae by Roman Labuda.

Check it out! From @rokaslab.bsky.social and Oberlies Lab @uncgresearch.bsky.social
Machine-Readable Structural Information Is Essential for Natural Products Research | Journal of Natural Products pubs.acs.org/doi/10.1021/...

Check it out! From @rokaslab.bsky.social and Oberlies Lab @uncgresearch.bsky.social
Machine-Readable Structural Information Is Essential for Natural Products Research | Journal of Natural Products pubs.acs.org/doi/10.1021/...
microbialcellfactories.biomedcentral.com/articles/10....
Scaling up natural products is a pivotal goal in our lab. With scaled-up pure compounds, one can begin to test the various applications of fungal natural products
@uncgresearch.bsky.social

microbialcellfactories.biomedcentral.com/articles/10....
Scaling up natural products is a pivotal goal in our lab. With scaled-up pure compounds, one can begin to test the various applications of fungal natural products
@uncgresearch.bsky.social
- Dr. Jane Goodall

- Dr. Jane Goodall


Discover just how important they are in 20 minutes 👇
ow.ly/u4fc50X2JRo

Discover just how important they are in 20 minutes 👇
ow.ly/u4fc50X2JRo

Natural product Chemists and Mycologists have lots of work to do!
Nice Perspective from the @rokaslab.bsky.social

Natural product Chemists and Mycologists have lots of work to do!
Nice Perspective from the @rokaslab.bsky.social
This is some work the Oberlies lab @uncg.edu did in collaboration with @rokaslab.bsky.social lab

This is some work the Oberlies lab @uncg.edu did in collaboration with @rokaslab.bsky.social lab
Read it to find out how population structure impacts pathogenicity in Aspergillus flavus, a fungus that infects humans 🧪
rdcu.be/eAToj

Read it to find out how population structure impacts pathogenicity in Aspergillus flavus, a fungus that infects humans 🧪
rdcu.be/eAToj
Our new review on the secondary metabolites of coprophilous fungi has just been published by Natural Product Reports. Thanks for funding from the @humboldt-foundation.de foundation.de, the @dfg.de & the @daadworldwide.bsky.social Congrats to all coauthors!

Our new review on the secondary metabolites of coprophilous fungi has just been published by Natural Product Reports. Thanks for funding from the @humboldt-foundation.de foundation.de, the @dfg.de & the @daadworldwide.bsky.social Congrats to all coauthors!
Nymphoides peltata occupies ~17 football ⚽ fields of area in Lake Mälaren & is in other spots too. We show that Septoria villarsiae & friends are associated with this host in 🇸🇪.
@zimingwang.bsky.social
zenodo.org/records/1653...

Nymphoides peltata occupies ~17 football ⚽ fields of area in Lake Mälaren & is in other spots too. We show that Septoria villarsiae & friends are associated with this host in 🇸🇪.
@zimingwang.bsky.social
zenodo.org/records/1653...
The peer-review crisis: how to fix an overloaded system www.nature.com/articles/d41...

The peer-review crisis: how to fix an overloaded system www.nature.com/articles/d41...
New Freshwater Ascomycete Genus from Indiana! Atromganispora indianensis



New Freshwater Ascomycete Genus from Indiana! Atromganispora indianensis
The world's worst industrial catastrophe continues to affect families with health conditions and paltry compensation. cen.acs.org/environment/... #chemsky 🧪

The world's worst industrial catastrophe continues to affect families with health conditions and paltry compensation. cen.acs.org/environment/... #chemsky 🧪
butterfly-conservation.org/news-and-blo...

butterfly-conservation.org/news-and-blo...






